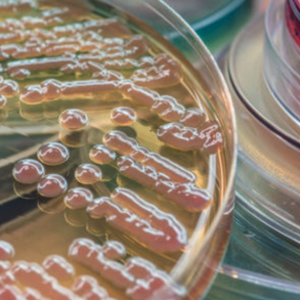
Enzymatic digest

Microbiology & BioPharma
Bacteriological A125 Global is an animal-free, seaweed derived product.
Gelidium Derived AgarProduct Applications: Gelling agent,
Product Class: Gum, Stabilizer,
Product Category: Microbiology & BioPharma
View Product
Bacteriological A128 Global is a pure Gelidium spp. Animal-free Seaweed derived alginate.
Gelidium Derived AgarProduct Applications: Gelling agent,
Product Class: Gum, Stabilizer,
Product Category: Microbiology & BioPharma
View Product
Beef Extract is a Powder Low fat, bovine Nitrogen source.
-Product Applications: Bacteriological examination of environmentals, Bacteriological examination of food, Bacteriological examination of water, Culture media,
Product Class: Meat extract,
Product Category: Microbiology & BioPharma
View Product
Bile Salts 3 is bovine derived and used as a selective media reagent and MacConkey’s Agar.
Ursodeoxycholic AcidProduct Applications: MacConkey's Agar, Selective media reagent,
Product Class: Bile products,
Product Category: Microbiology & BioPharma
View Product
Casamino Acid is a Powder Casein Hydrolysate/complete acid digest of casein.
-Product Applications: Antibiotic resistance testing, Mueller-Hinton agar,
Product Class: Peptones,
Product Category: Microbiology & BioPharma
View Product
Casein Peptone Type 1 is a Powder Pancreatic digest of casein containing all the amino acids found in casein.
Casein Protein HydrolysateProduct Applications: Animal health, Pharma,
Product Class: Peptones,
Product Category: Microbiology & BioPharma
View Product
CE90CPP is a milk protein hydrolysate containing casein phosphopeptides and is manufactured using food grade enzymes.
Casein Phophopeptides ComplexProduct Applications: Pharma,
Product Class: Hydrosa, Peptones, Protein,
Product Category: Microbiology & BioPharma
View Product
CE90M is Partial Digest of Casein.
Casein Peptone HydrolysateProduct Applications: Animal health vaccines, Industrial fermentation, Toxin production,
Product Class: Peptones,
Product Category: Microbiology & BioPharma
View Product
Corn Steep Liquor Powder is powder corn derived and is used in industrial fermentation.
-Product Applications: Industrial fermentation,
Product Class: Carbohydrate source,
Product Category: Microbiology & BioPharma
View Product
CR90ML is Powder hydrolysate of casein.
Casein Protein HydrolysateProduct Applications: Animal health vaccines, Industrial fermentation, Toxin production,
Product Class: Peptones,
Product Category: Microbiology & BioPharma
View Product
Enzymatic Digest of Animal Tissue is a Powdered Peptic Digest of Animal Tissue (Peptone A).
-Product Applications: Food safety testing, Listeria pre-enrichment media,
Product Class: Meat extract,
Product Category: Microbiology & BioPharma
View Product
Proyield Whey LE80MX is a Lactalbumin hydrolysate complex, comprised of whey-based nitrogen source material for the cultivation of Lactic Acid Bacteria used in Probiotic formulations for high performance human and animal health products.
Whey Protein and Casein Hydrolysate - Lactalbumin hydrolysateProduct Applications: Animal health vaccines, Culture media, Probiotics, Toxin production,
Product Category: Microbiology & BioPharma
View Product